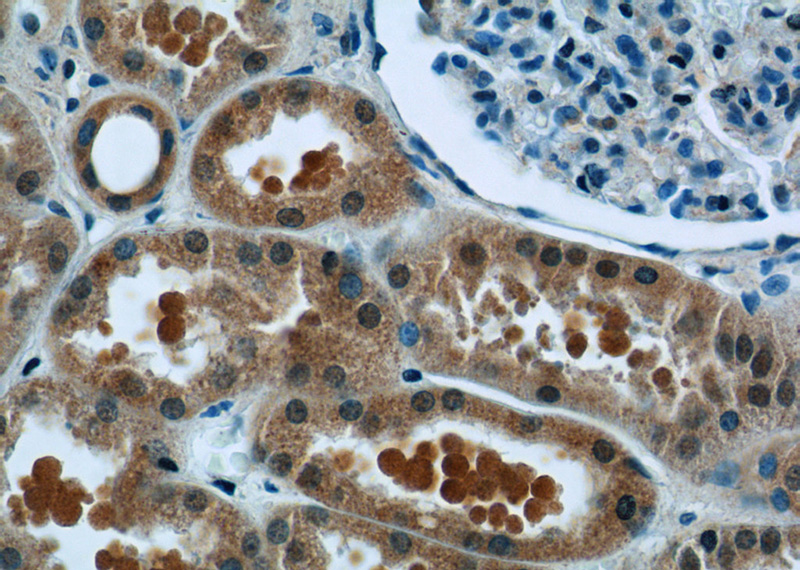
Immunohistochemistry of paraffin-embedded human kidney tissue slide using Catalog No:115919(TCTN1 Antibody) at dilution of 1:50 (under 40x lens)

-
Product Name
TCTN1 antibody
- Documents
-
Description
TCTN1 Rabbit Polyclonal antibody. Positive IF detected in hTERT-RPE1 cells. Positive IHC detected in human kidney tissue. Positive WB detected in mouse embryo tissue. Observed molecular weight by Western-blot: 55-64kd
-
Tested applications
ELISA, WB, IF, IHC
-
Species reactivity
Human,Mouse,Rat; other species not tested.
-
Alternative names
FLJ21127 antibody; TCTN1 antibody; TECT1 antibody; Tectonic 1 antibody; tectonic family member 1 antibody
-
Isotype
Rabbit IgG
-
Preparation
This antibody was obtained by immunization of TCTN1 recombinant protein (Accession Number: NM_001082537). Purification method: Antigen affinity purified.
-
Clonality
Polyclonal
-
Formulation
PBS with 0.02% sodium azide and 50% glycerol pH 7.3.
-
Storage instructions
Store at -20℃. DO NOT ALIQUOT
-
Applications
Recommended Dilution:
WB: 1:500-1:5000
IHC: 1:20-1:200
IF: 1:10-1:100
-
Validations

mouse embryo tissue were subjected to SDS PAGE followed by western blot with Catalog No:115919(TCTN1 antibody) at dilution of 1:800

IF result from Dr. Corbit, Kevin. anti-TCTN1(Catalog No:115919) mark the transition zone of Human hTERT-RPE1 cells.
Immunohistochemistry of paraffin-embedded human kidney tissue slide using Catalog No:115919(TCTN1 Antibody) at dilution of 1:50 (under 40x lens)
-
Background
Tectonic-1, encoded by TCTN1 (TECT1) gene, belongs to the tectonic family of secreted and transmembrane proteins. Tectonic-1 is a component of the tectonic-like complex, a complex localized at the transition zone of primary cilia and acting as a barrier that prevents diffusion of transmembrane proteins between the cilia and plasma membranes. Multiple transcript variants encoding different isoforms have been found for this gene. Defects in TCTN1 are the cause of Joubert syndrome type 13 (JBTS13), a disorder presenting with cerebellar ataxia, oculomotor apraxia, hypotonia, neonatal breathing abnormalities and psychomotor delay.During neural tube development, mouse Tectonic is required for formation of the most ventral cell types and for full Hedgehog (Hh) pathway activation. Epistasis analyses reveal that Tectonic modulates Hh signal transduction downstream of Smoothened (Smo) and Rab23.
-
References
- Garcia-Gonzalo FR, Corbit KC, Sirerol-Piquer MS. A transition zone complex regulates mammalian ciliogenesis and ciliary membrane composition. Nature genetics. 43(8):776-84. 2011.
- Chih B, Liu P, Chinn Y. A ciliopathy complex at the transition zone protects the cilia as a privileged membrane domain. Nature cell biology. 14(1):61-72. 2012.
- Joo K, Kim CG, Lee MS. CCDC41 is required for ciliary vesicle docking to the mother centriole. Proceedings of the National Academy of Sciences of the United States of America. 110(15):5987-92. 2013.
- Wang WJ, Tay HG, Soni R. CEP162 is an axoneme-recognition protein promoting ciliary transition zone assembly at the cilia base. Nature cell biology. 15(6):591-601. 2013.
- Lu H, Toh MT, Narasimhan V, Thamilselvam SK, Choksi SP, Roy S. A function for the Joubert syndrome protein Arl13b in ciliary membrane extension and ciliary length regulation. Developmental biology. 397(2):225-36. 2015.
- Barbelanne M, Hossain D, Chan DP, Peränen J, Tsang WY. Nephrocystin proteins NPHP5 and Cep290 regulate BBSome integrity, ciliary trafficking and cargo delivery. Human molecular genetics. 24(8):2185-200. 2015.
Related Products / Services
Please note: All products are "FOR RESEARCH USE ONLY AND ARE NOT INTENDED FOR DIAGNOSTIC OR THERAPEUTIC USE"
